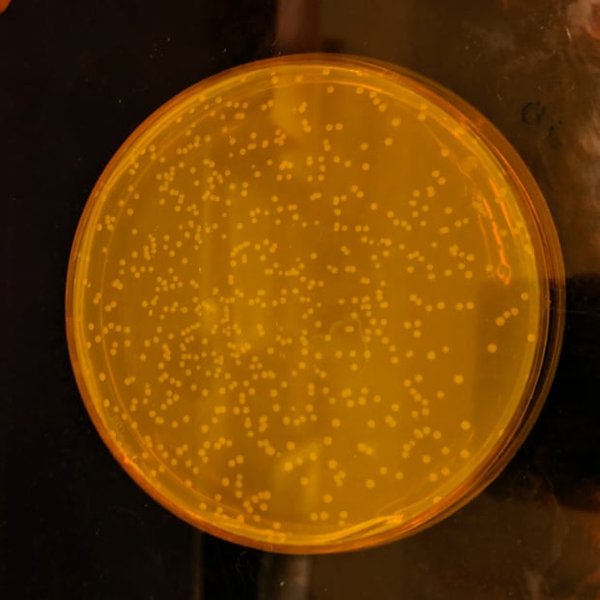

Ученые создали живой организм с полностью искусственной ДНК

Таким образом можно создавать "лечебные" бактерии с заданными свойствами, например, с устойчивостью к вирусам
Биологи из Кембриджского университета создали штамм кишечной палочки Escherichia coli, геном которой был радикально изменен и синтезирован искусственно. Об этом пишет The Guardian.
Молекула ДНК хранит биологическую информацию в виде генетического кода, состоящего из последовательности нуклеотидов. Нуклеиновые кислоты A, C, T, G объединяются в 64 комбинации трехбуквенных "слов", так называемых кодонов, которые отвечают за синтез белков. Почти все живые организмы, от медузы до человека, имеют 64 кодона, при этом некоторые из них выполняют одни и те же функции.
Изучая синтез белка кишечной палочке, ученым удалось выявить взаимозаменяемые кодоны и "урезать" генетический код, а затем по частям синтезировать его химически. В записи код занимает 970 страниц формата А4. Это самый большой искусственный геном из когда-либо созданных.
"До последнего мы не знали точно, можно ли сделать геном таким большим и можно ли его изменить так сильно изменить", - говорит эксперт по синтетической биологии Джейсон Чин. По его словам, результаты исследования могут быть использованы в фармацевтической промышленности для создания "лечебных" бактерий с заданными свойствами, например, с устойчивостью к вирусам. Так, E coli уже используется для производства инсулина от диабета, а также других медицинских препаратов для лечения рака, рассеянного склероза, сердечных приступов и заболеваний глаз.
Другие новости о ДНК:
- Ученые впервые проанализировали ДНК человека с помощью алгоритма глубокого обучения. Оказалось, что помимо неандертальцев и денисовских людей, у современных людей есть еще один предок - гибрид этих двух вымерших видов.
- После скандала с китайским ученым, создавшим первых CRISPR-близнецов, генетики призвали к мораторию на редактирование геномов детей как минимум на 5 лет.